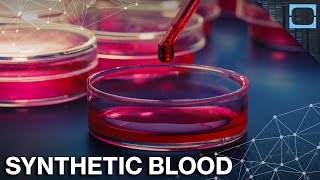
Can Synthetic Blood Help The World's Blood Shortage?

Song info
"Power In The Blood" Videos
Lyrics
Would you be free from the burden of sin?
There's power in the blood, power in the blood;
Would you o'er evil a victory win?
There's wonderful power in the blood.
There is power, power, wonder working power
In the blood of the Lamb;
There is power, power, wonder working power
In the precious blood of the Lamb.
Would you be free from your passion and pride?
There's power in the blood, power in the blood;
Come for a cleansing to Calvary's tide;
There's wonderful power in the blood.
Would you be whiter, much whiter than snow?
There's power in the blood, power in the blood;
Sin stains are lost in its life giving flow.
There's wonderful power in the blood.
Would you do service for Jesus your King?
There's power in the blood, power in the blood;
Would you live daily His praises to sing?
There's wonderful power in the blood
- 0 Bản dịch
Hiện tại chưa có lời dịch cho bài hát này. Bạn hãy là người đầu tiên chia sẻ lời dịch cho bài hát này nhé !
Đăng lời dịchAlbums has song "Power In The Blood"

Singles
15 songs
- Armor Of God 2007
- Serve The Lord 2007
- Keep The Temple Pure 2007
- El Diablo 2007
- Christian Band 2007
- Christ Is Calling 2007
- Be A Living Sacrifice 2007
- Silence Is A Weakness 2007
- Don't Be Like The World 2007
- Change 2007
- Father's House 2007
- Satan Wants Me Dead 2007
- 70 X 7 2007
- Salt And Light 2007
- Power In The Blood 2007

Singles
15 songs
- Armor Of God 2007
- Serve The Lord 2007
- Keep The Temple Pure 2007
- El Diablo 2007
- Christian Band 2007
- Christ Is Calling 2007
- Be A Living Sacrifice 2007
- Silence Is A Weakness 2007
- Don't Be Like The World 2007
- Change 2007
- Father's House 2007
- Satan Wants Me Dead 2007
- 70 X 7 2007
- Salt And Light 2007
- Power In The Blood 2007






![Killswitch Engage - Holy Diver [OFFICIAL VIDEO]](https://img.youtube.com/vi/NR7dG_m3MsI/mqdefault.jpg)

Recent comments